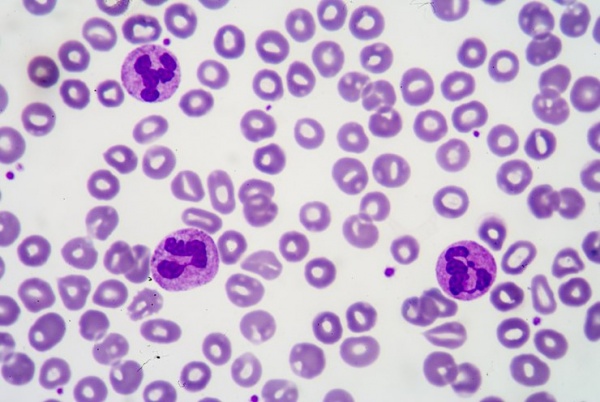
Подсчет эозинофилов может помочь в раннем выявлении COVID-19 у пациентов

Ученые работают над использованием нанотехнологии в бактериологических исследованиях
Исследователи из Бохума, Геттингена, Дуйсбурга и Кельна разработали новый метод обнаружения бактерий и связанных с ними инфекций.
Ваш еженедельный источник новостей, актуальной информации о клинической лабораторной диагностике. Авторами материалов являются сотрудники компании ОМБ – специалисты с глубокими познаниями в этой области. Это не просто новостные сводки, а полноценные статьи, основанные на тщательном анализе научных данных и тенденциях последних исследований, где каждый материал дополнен мнениями и комментариями ведущих экспертов ОМБ.

Исследователи из Бохума, Геттингена, Дуйсбурга и Кельна разработали новый метод обнаружения бактерий и связанных с ними инфекций.

В некоторых исследованиях сообщалось о различных электролитных нарушениях при поступлении у пациентов, у которых позже была обнаружена тяжелая форма COVID-19.
Электролитный дисбаланс может не только повлиять на лечение пациента, но и дать представление о патофизиологии COVID-19.

Выбор методики отбора крови у пациентов одна из наиболее плохо изученных проблем при разработке плана лечения пациентов с острыми и хроническими заболеваниями. Альтернатива стандартной венепункции может значительно повысить способность лаборатории проводить тестирование.

Период пандемии коронавируса изменил подход к маркетингу каждой частной клиники. Да и в целом, за последние 9 месяцев текущей ситуации вся индустрия частной медицины изменилась больше, чем она менялась за последнее десятилетие.

Несмотря на устойчивую фармакологическую базу, результаты клинических исследований в подборе дозы варфарином на основе фармакогенетики выдали сомнительные результаты, что привело к сокращению его использования.
Экспресс-лабораторный тест, подсчет эозинофилов, который можно легко получить из обычного общего анализа крови (CBC), может помочь в раннем распознавании COVID-19 у пациентов, а также предоставить прогностическую информацию, согласно новому исследованию в The Journal of the American Osteopathic Association.

Недавно состоялась очередная онлайн-конференция МарТех, в которой приняли участие эксперты в области медицины. В ходе обсуждения речь шла о текущих трендах, маркетинговых технологиях и коронакризисе и его влиянии на рынок медицинских услуг. В нашем материале подробно расскажем, к каким выводам пришли эксперты.

Короновирусная инфекция COVID-19 распространилась по всему миру. Хотя у нас уже есть определенное представление о характере данного заболевания, влияние вируса на функции и метаболизм человека еще предстоит полностью изучить.

SARS-CoV-2 впервые был зарегистрирован в Ухане, провинция Хубэй (Китай) в конце декабря 2019 года.
С тех пор он заразил большую часть населения всего мира: в настоящее время число заболевших SARS-CoV-2 превышает 31 миллион, COVID-19 унес жизни более 960 000 человек.
Внимание!
Размещенная на сайте www.omb.ru информация (в том числе рекламного характера), а также графические образы и изображения медицинских изделий представлены исключительно для сотрудников медицинских организаций/медицинских работников - пользователей медицинских изделий и поставщиков медицинских изделий.
Нажимая на кнопку «Продолжить» и оставаясь на указанном сайте, вы подтверждаете, что являетесь медицинским работником, либо поставщиком медицинских изделий и принимаете на себя ответственность за несоблюдение указанного ограничения.